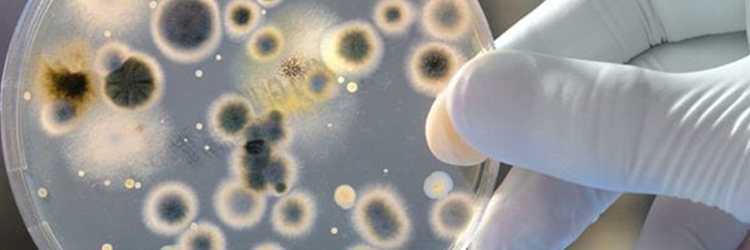
autóklíma tisztítás ár

Biztosan előfordult már életük során azokkal az autótulajdonosokkal, akik autóklímával rendelkeznek, hogy a készülék bekapcsolását követően dohos, áporodott szag árasztotta el a kocsit. Netalántán egy barát vagy családtag ült be az anyósülésre és köhögni-tüsszögni kezdett a légkonditól, mondván hogy allergiás vagy csupán túl száraz a levegő. Legtöbben legyintenek ezekre az apró kellemetlenségekre, hiszen pár perc után hozzászokik az ember. Azonban hosszútávon akarva-akaratlanul károsíthatjuk saját- és családtagjaink egészségét, pedig évente egy-két autóklíma tisztítás orvosolhatná ezt a problémát.
Második otthonunk, törődjünk is úgy vele
Bele sem gondolnánk éves szinten mennyi időt töltünk el autónkban, akár munkába járva, akár szabadidős tevékenység céljából. Tegyük fel egy átlagos hétköznap reggel dolgozni indulunk, a munkahely háromnegyed órányi kocsikázásra van, de előtte a gyerekeket még elvisszük iskolába, ami mondjuk legyen egy 15 perces kitérő. Alig kezdődött el a nap, de már egy órát kocsikáztunk. A munkaidő leteltével hazafelé megtesszük ugyanezt a távot, esetleg beugrunk a városba egy megrendelt csomagért, vagy elvisszük vacsorázni a családot. A napi átlag autóban töltött idő alaphangon 2-3 óra környékére ugrik, a hétvégi nagyszülő látogatást vagy városnézést bele sem kalkulálva. Máris láthatjuk miért válik második otthonunkká a családi autó, azonban mégsem takarítjuk olyan rendszerességgel, mint lakásunkat. A kocsimosón és a belső porszívózáson túl vannak olyan helyek, ahová nehezen vagy egyáltalán nem érünk el. Ilyen a klíma tisztítás autó esetében, ugyanis az elpárologtató nehezen hozzáférhető része a berendezésnek, és ha nem megfelelően végezzük, kárt tehetünk az elektronikában. Éppen ezért érdemes az autóklíma tisztítás kivitelezését szakember segítségére bízni.
Ózonos klímatisztításról bővebben >>
Mi minden telepedhet meg a légkondiban?
Elsősorban a légkondícionáló működési sajátosságának köszönhető, hogy egyes mikroorganizmusok tökéletes élőhelyként tekintenek erre a készülékre. A hideg és meleg levegő váltakoztatásával és áramoltatásával víz fog kiülni a rendszer belsejében, ami helyzettől függően vagy elpárolog, vagy nem. Sajnos legtöbbször a lefolyó pára megmarad és pangó vizes állapotot hoz létre a berendezésben. Autóklíma tisztítás nélkül, ebben a kis mennyiségű vízben kiválóan meg tudnak telepedni a levegőből bekerülő baktériumok és vírusok, a gombaspórák pedig csírázásnak indulnak. Ez nem azt jelenti, hogy csiperkét szüretelhetünk hónap végén, hanem a különböző penészek fognak terjedésnek indulni. Rövid szaporodási ciklusuknak köszönhetően újra spóratermelésbe kezdenek, amelyet belélegezve nagyon kellemetlen tüneteket okozhatnak, és a köhögés csak a kezdet. A különböző betegségeket terjesztő, szemmel láthatatlan mikroorganizmusokon túl, a por és a benne lévő poratkák ugyanúgy jól érzik magukat, akár hosszútávon is, ami az allergiások életminőségét tovább ronthatja. Ennek tekintetében az autóklíma tisztítás ár igazán megéri, hogy megőrizhessük egészségünket. Másrészt olyan élettelen részecskék és anyagok is bekerülhetnek a rendszerbe, amelyeket belélegezve szintén légúti betegségek megjelenését és allergia kialakulását kockáztatjuk. Ilyen lehet a kisállatszőr, még akkor is, ha sosem volt házikedvencünk az autóban vagy mi magunk nem vagyunk rá allergiásak. Elég egy macskaszőrös pulóverben beülni és leporolni magunkat, ami pillanatokon belül bekerül a klíma keringető rendszerébe.
Különböző penészgombák tenyészetei
Milyen autóklíma tisztító módszerekkel találkozhatunk?
Manapság egyre több, ugyanazon a módszeren alapuló tisztítószernek reklámozott dologgal találkozhatunk, egyik ilyen például a bombaként emlegetett eszköz, amely konkrétan füstbombaként működik. Ez azonban a látványosságtól eltekintve nem túl hatékony autóklíma tisztító, ezért ne lepődjünk meg, ha néhány ezer forintért szinte csak légfrissítőt sikerül vásárolnunk.
Másik gyakori módszer a habos vagy folyadékos fertőtlenítés, amiből nagyon sokfélét forgalmaznak a gyártók, viszont itt már máshogy működik a klíma tisztítás autó belterében, ugyanis ehhez már szét kell szedni a berendezést. Másik nagy hátránya, hogy „csak úgy” a klímába fecskendezve vagy fújva olyan vezetékeket és elektronikát érhet el, ami többszázezres kárt tehet a járműben. Hatásmechanizmusa azon alapszik, hogy a rendszerbe fújt hab kitölti a teret és lassan elfolyósodva kiürül a rendszerből. Viszont a nem megfelelően kiszellőztetett és visszamaradt vegyi anyagokat ugyanúgy nem egészséges belélegezni, mint a már említett mikrobákat.
Napjainkban egyre gyakoribb azonban az autóklíma tisztítás ózon segítségével, amit egy generátor működtetésével áramoltatnak keresztül a kocsi belterében. Esetünkben ugyanarról az ózonról beszélünk, amely körülöleli bolygónkat, valamint gyakran alkalmazzák fertőtlenítés céljából is. Egyik előnye, hogy vegyszermentesen működik, ezért tökéletesen megfelel autó légkondi tisztítás céljából.
Ózonos klímatisztításról bővebben >>
Miért ennyire hatékony az ózonos autóklíma tisztítás?
Az ózon (O3) az egyik legerősebb oxidálószer, ezért kiválóan alkalmas a kellemetlen szagok megszüntetésére és a betegségeket okozó mikroorganizmusok elpusztítására. Mindemellett fontos tényező, hogy vegyszermentes hatásmechanizmusának köszönhetően környezetkímélő módszer. A folyamat során az ózon (kevésbé stabil molekula révén) leadja a harmadik oxigén atomját, amely egy másik ózonmolekula által leadott atommal összekapcsolódik, létrehozva a minket körülvevő oxigén molekulákat (O2). Ennek azonban idő szükséges, ezért az ózonos autóklíma tisztító generátor lekapcsolása után 15-20 percig szellőztetni kell a belteret. Hatékonyságát tekintve az autóklíma tisztítás ár szinte elhanyagolható. A fertőtlenítés során a legkisebb rést is átjárja az ózon, így sikeresen elpusztít minden élő szervezetet: penészt, baktériumokat, poratkákat, de még a sarokban megbújó pókokat is. Itt fontos megjegyezni, hogy oxidáló hatása révén minden szervezetre károsítólag hat, bizonyos koncentráció felett mérgező hatású. Emiatt a kezelés során autóban ülni, kisállatot (esetleg növényt) az autóban hagyni szigorúan tilos, azonban a bomlást követően semmilyen veszélyeztető faktor nincs. Erős szagtalanító hatásának köszönhetően nem csak az autó légkondi tisztítás végezhető el, de az üléskárpitra kiöntött kávé vagy nemrég szállított (esetleg esőben elázott) háziállat szagát is nyomtalanul eltünteti. A tisztítást követően az autó beltere újra friss és kellemes illatúvá válik, mintha csak az erdőben járnánk. Az autóklíma tisztítás ózon használatával nem véletlen, hogy ipari és mezőgazdasági alkalmazása egyre inkább terjedőben van.

Ne csak külsőre legyen tiszta a klímánk!
Mikor ajánlott az autóklíma tisztítás ózon bevetésével?
Amennyiben hatékonyan és alaposan szeretnénk elvégeztetni az autó légkondi tisztítás kivitelezését, és szakemberre bíznánk a dolgot, érdemes az ózongenerátoros módszert választani. Ehhez a folyamathoz nincs szükség a műszerfal megbontására, hogy hozzáférhessünk a klímaberendezés belső részeihez. Ezt elvégzi helyettünk a magas koncentrációjú ózon, amit zárt térben keringetünk és elér a kocsi minden apró zugába. Kisgyerekes szülők és légúti megbetegedéssel küzdők (mint az allergiások és asztmások) esetében határozottan ajánlott tisztítási mód. Az autóklíma tisztítás ár a szolgáltatás értékével fordítottan arányos, azaz jó minőségű fertőtlenítő kezelést kapunk potom fizetségért. Vegyszermentesen alkalmazható, ezért nem kell visszamaradó foltoktól és vegyszerszagtól tartanunk, sőt a kezelést követően friss illat fogad majd minket. Előfordulhatnak olyan problémák és káresetek, amelyek során erőteljes, zavaró szag ivódik az autó minden részébe, ilyen lehet például egy beázás vagy égés. Beázás során is elszaporodhatnak a penészgombák, amely dohos szagot eredményez. Az égett szagot is sokan ismerik, vagy gondoljunk akár az autóban történő dohányzásra, amellyel autóvásárlás esetén is találkozhatunk. Az ózonos klíma tisztítás autó belsejében ezekre a problémákra is könnyűszerrel megoldást nyújt, hiszen tartósan szünteti meg a szagokat. Amennyiben úgy érzi aktuálissá vált az autóklíma tisztítás Debrecen területén megtalál minket, forduljon hozzánk bizalommal!
